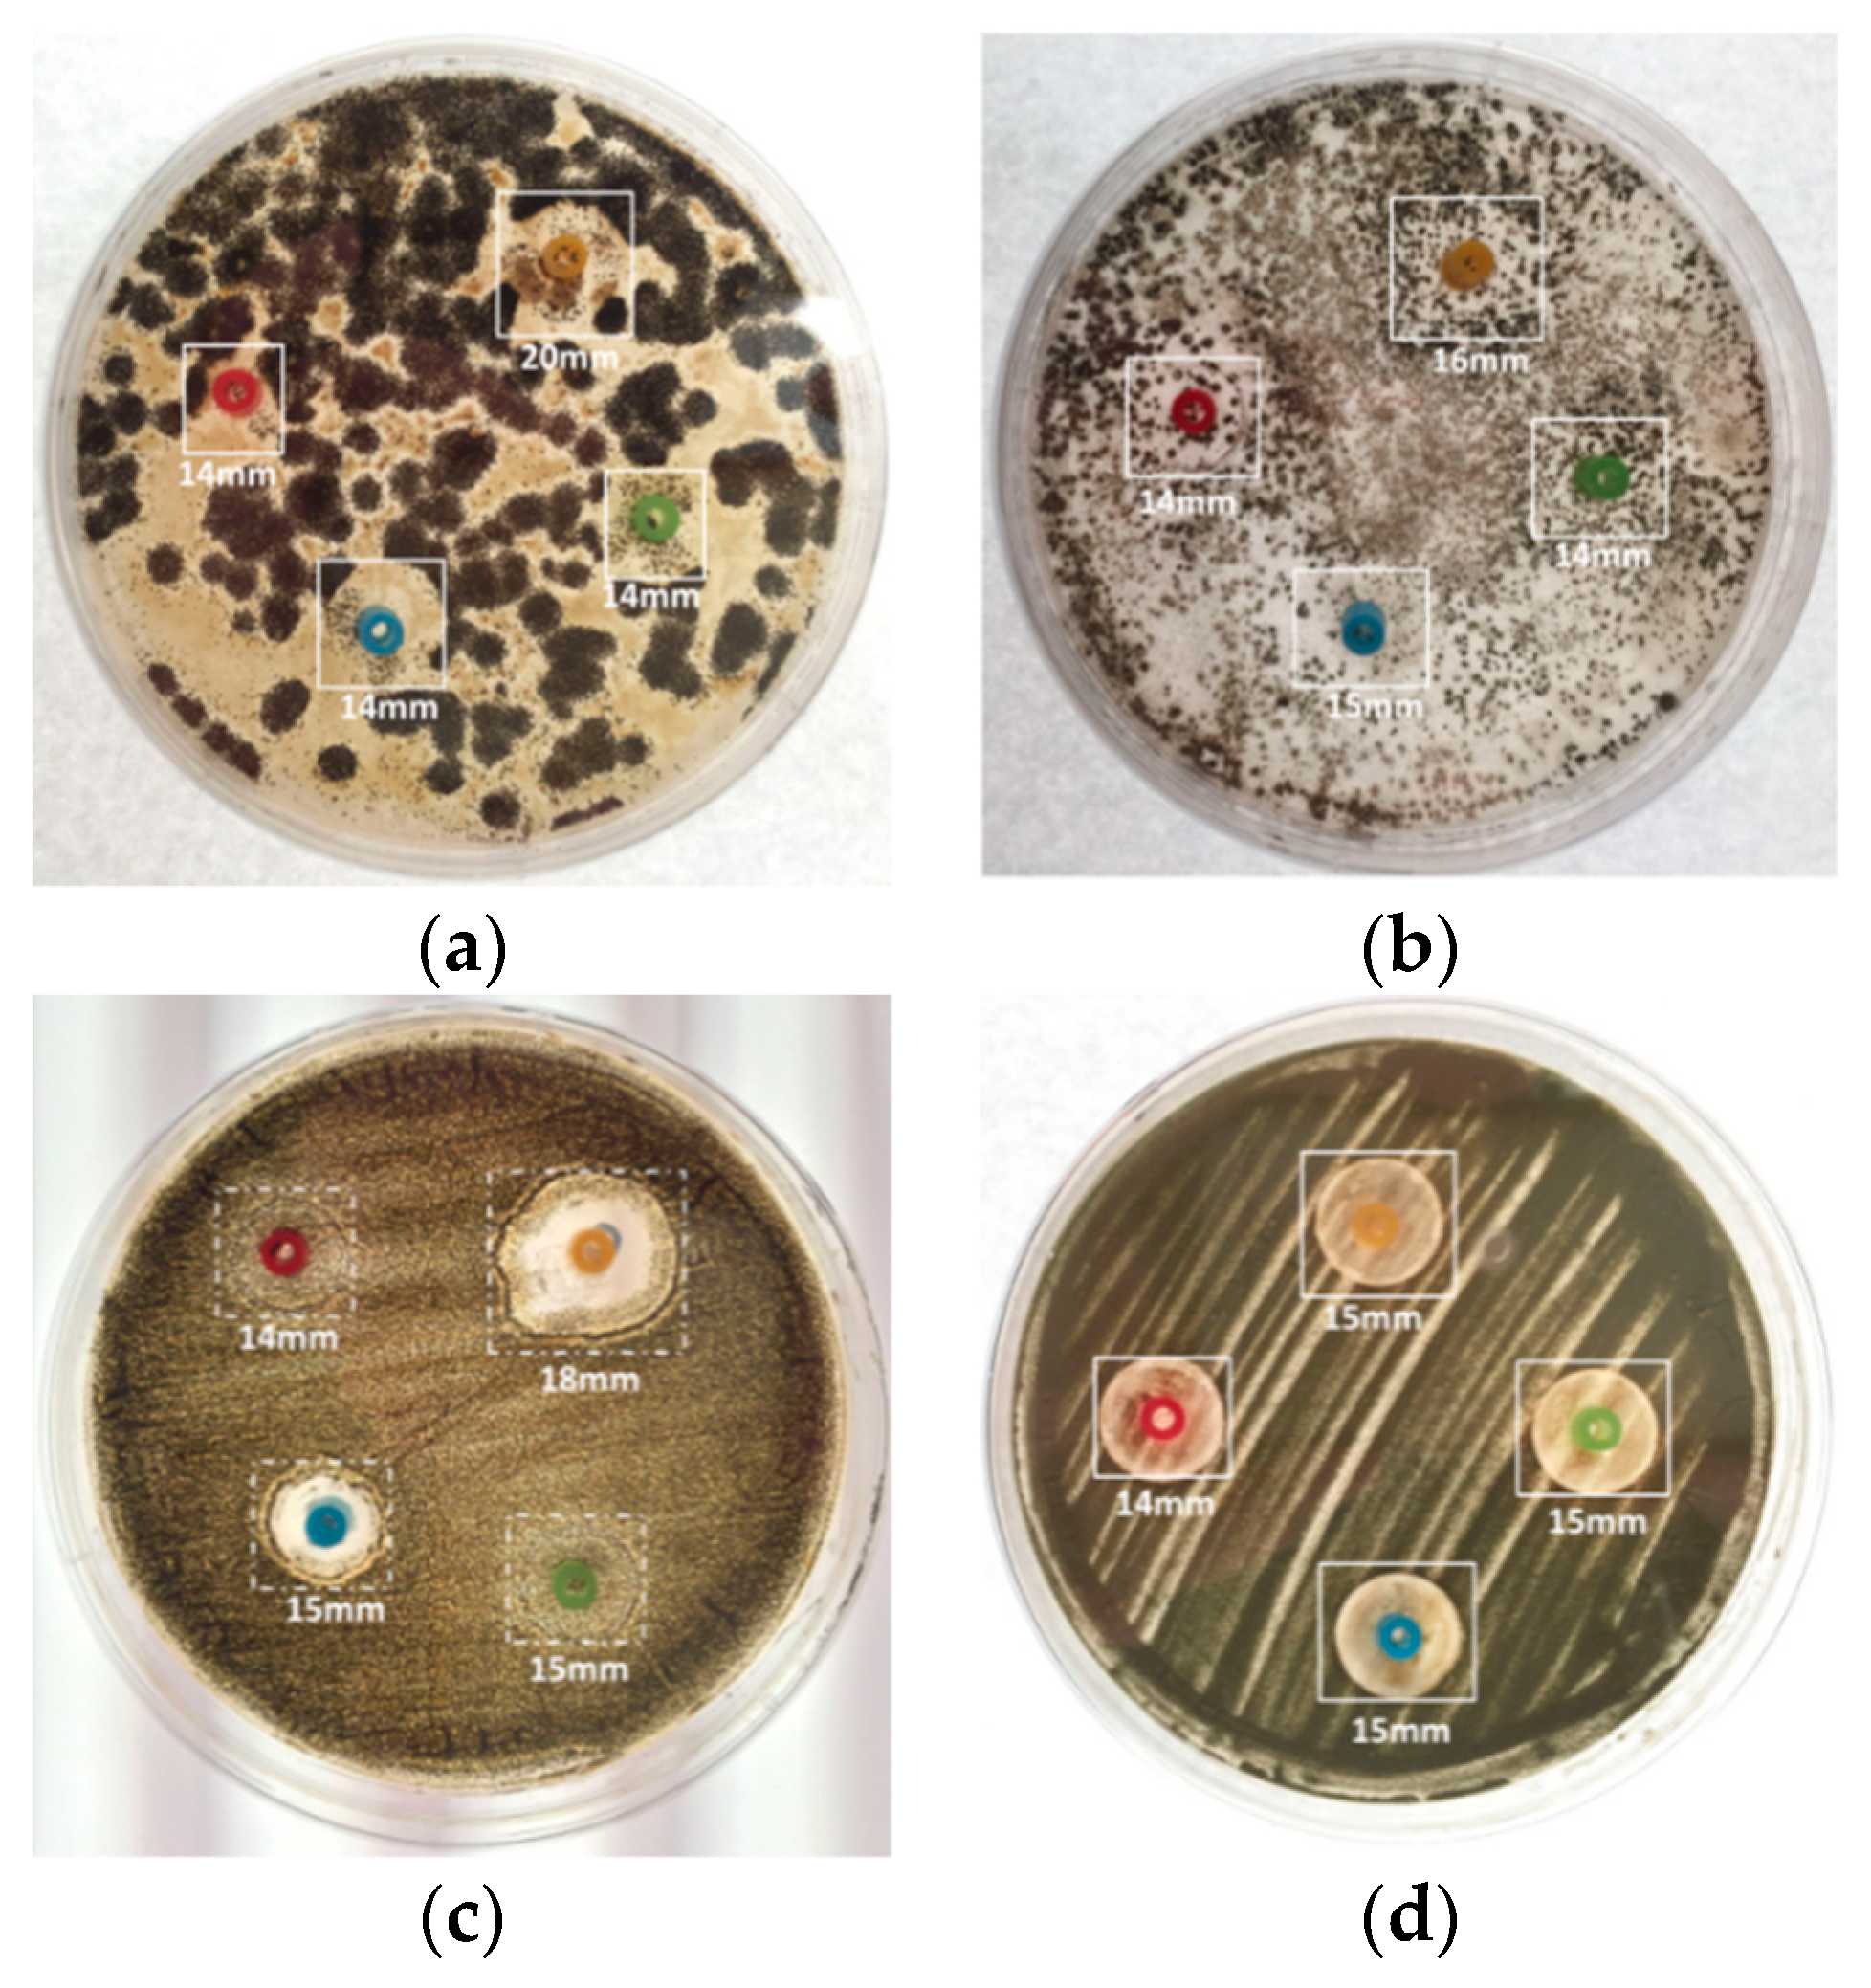
Micromachines 13 00790 g011

Implementation of Micro-EDM Monitoring System to Fabricate Antimicrobial Nanosilver Colloid
Abstract
:1. Introduction
2. Materials and Methods
2.1. Preparation of Nanosilver Colloid by Electrical Spark Discharge Method (ESDM)
- Power system: 100 DC volts and above;
- Servo control system: controls the z-axis motor to maintain the two electrodes at a distance of micrometers;
- Parameter control panel: adjusts the discharge cycle or z-axis speed, etc.
- Discharge failure (situation 1): There is voltage without a current. This is the same as with an open circuit.
- Discharge failure (situation 2): As the two electrodes are very close, it is likely to cause a short circuit, similar to a current without voltage.
- Discharge success: The spark damages the DW insulation and successfully generates a spark discharge. In addition, there are voltage and a current at the same time.
- Absorption peak: The instrument will emit UV and visible light to radiate the object under analysis. Through the sensor receiving the light, it can measure the absorption peak of each wavelength of the colloid. Higher absorption peaks suggest higher concentrations of colloid at the wavelength. On the contrary, a lower absorption rate suggests a lower concentration of colloid [33,34,35].
2.2. Activation and Cultivation of Strains
2.2.1. Inhibition Zone Test
- Test solution preparation: NO.1 was the nanosilver colloid made using the micro-EDM, with a silver ion concentration of 5 ppm. NO.2 was the nanosilver colloid produced by the traditional EDM; the silver ion concentration was 32 ppm, and the silver particle concentration was about 300 ppm. NO.3 was the nanosilver colloid produced by the micro-EDM; while the silver ion concentration was 5 ppm, the nanoparticle was the smallest. NO.4 was a 32 ppm silver ion titer.
- Fungus sample preparation: There are four kinds of fungus samples: (a) the strain was randomly collected from the dim and damp parts of a bathroom; the strain was smeared on the Potato Dextrose Agar (PDA) and cultured; (b) penicillium: the strain was collected from moldy oranges; the strain was smeared on PDA and cultured; (c) Aspergillus Niger: pure strain was bought from BCRC (Bioresource Collection and Research Center, Hsinchu, Taiwan); the strain was smeared on Malt Extract Agar (MEA) and cultured; (d) Aspergillus Flavus: pure strain was bought from BCRC; the strain was smeared on PDA and cultured. The bathroom sample, Penicillium, Aspergillus niger, and Aspergillus flavus are the four targets in this study. These are widespread both indoors and outdoors, and those exposed to them will sometimes have allergies, get sick, or suffer an infection or other conditions that may harm the body. These four targets are easily obtained, simple to cultivate, and most importantly, they are often sources of trouble in normal life in Taiwan (due to the wet weather). Therefore, this study used the micro-EDM to fabricate a nanosilver colloid that can inhibit the four targets [43,44].
- Experimental method design: Inhibition zone test: the size of the inhibition zones formed by the NO.1~NO.4 test solutions in four fungus culture media were observed in order to judge the microbial control effect of each test solution. The test process is shown in Figure 4. The test configuration is shown in Table 1. The NO.1~NO.4 test solutions were injected into the inhibition zones in the culture media cultivating different strains, respectively. The corresponding color labels are: NO.1 (Red), NO.2 (Yellow), NO.3 (Green), NO.4 (Blue).
2.2.2. Microbial Control Cotton Pad Test
3. Results
3.1. The Results of the Nanosilver Colloid
3.2. Microbial Control Cotton Pad Test Results and Discussion
3.3. The Results and Discussion of Inhibition Zone Tests
- In the inhibition zone test, the metal ring was placed on the culture medium, and the test solution was then injected into the metal ring [48]. The test solution was slowly absorbed by the culture medium before the metal ring was removed. If the metal ring is removed before the test solution is dried up, the flow of the test solution may influence the experimental results.
- The microbial control cotton pad test was an improvement proposed for inhibition zone testing [49,50]. Compared to the experiment with the metal ring, in which the test solution needs to be injected in the middle of the ring, the cotton pad holds water, so the test solution will not flow on the culture medium, and the waiting time for drying during the experiment can be shortened.
- The microbial control cotton pad test results were relatively objective and observable. It was observed that the NO.2 and NO.4 test solutions had the best microbial control effects.
- The inhibition zone test was implemented for four kinds of fungi in the NO.1~NO.3 nanosilver colloids with different concentrations and characteristics and the NO.4 Ag+ standard solution. It was observed that the NO.2 32 ppm nanosilver colloid had the best microbial control effect, then the NO.4 Ag+ standard solution at the same concentration. It may be that, because the silver nanoparticles release Ag+ continuously at the same Ag+ concentration, the microbial control effect is better than the standard Ag+ solution. While the concentration of the NO.1 and NO.3 nanosilver colloids was about 5ppm, NO.3 had the smallest silver nanoparticle, meaning a larger contact surface area and the highest zeta potential; thus, its microbial control effectiveness was better than NO.4.
4. Conclusions
- The user may adjust the successful discharge times, electrode energy consumption, and discharge success rate at any time to obtain the optimal parameters to fabricate the nanosilver colloid using the Electrical Spark Discharge Method.
- In the inhibition zone experiment, this study proposes use of the microbial control cotton pad. The microbial control cotton pad is characterized by its low cost, quick experimentation, and easy observation. It is unlikely to fail, and there is no metal ring; thus, the presentation of the inhibition zone will match the actual result better.
- In the NO.1 liquid, the effects were inhibited at 14 mm in all four samples in the metal ring experiment and at 17 mm in Penicillium in the cotton pad experiment. In the metal ring experiment, the NO.2 liquid had an effect at 20 mm in the bathroom samples and a 15 mm inhibited effect on flavus. In the cotton pad experiment, the inhibited effect was more effective in Penicillium and Aspergillus Niger, both with an inhibited effect at 25 mm. The NO.3 and NO.4 liquids had a14–15 mm effect on all samples in the metal ring experiment. In the cotton pad experiment, NO.3 had an effect on Penicillium at 19 mm, while its effect on the others was only 14 mm. NO.4 had an effect of 25 mm on Penicillium and Aspergillus Niger and only 14mm on the bathroom and Aspergillus flavus samples.
- The inhibition zone experiment found that the Ag+ and nanosilver colloids have a better microbial control effect on penicillium and Aspergillus niger and a worse effect on Aspergillus flavus.
- Although this study has verified that a nanosilver colloid made using an EDM has microbial control effects, it is only a small step. The issue of nanomaterials is a big subject in terms of antibacterial, biomedical, and environmental aspects. All of the research topics are only just beginning. It is worth investing in more research to benefit more people in the near future.
Author Contributions
Funding
Data Availability Statement
Acknowledgments
Conflicts of Interest
Abbreviations
| Electrical Discharge Machine (EDM) | Direct Current (DC) |
| Micro-Electrical Discharge Machine (micro-EDM) | Potato Dextrose Agar (PDA) |
| Electrical Spark Discharge Method (ESDM) | Bioresource Collection and Research Center (BCRC) |
| Deionized Water (DW) | Malt Extract Agar (MEA) |
References
- Roco, M.C.; Bainbridge, W.S. Converging Technologies for Improving Human Performance: Nanotechnology, Biotechnology, Information Technology and Cognitive Science; Springer Science & Business Media: Berlin, Germany, 2013. [Google Scholar]
- Aithal, S.; Aithal, P.S. Green and Eco-friendly Nanotechnology—Concepts and Industrial Prospects. Int. J. Manag. Technol. Soc. Sci. 2021, 6, 1–31. [Google Scholar] [CrossRef]
- Roukes, M. Plenty of Room, Indeed. Sci. Am. 2007, 9, 48–57. [Google Scholar] [CrossRef]
- Gajbhiye, S.; Satish, S. Silver nanoparticles in cosmetics. J. Cosmet. Dermatol. Sci. Appl. 2016, 6.1, 48–53. [Google Scholar] [CrossRef] [Green Version]
- Yang, L.; Liu, F.; Chen, Y.; Liu, Z.; Zhang, G. Research on the Treatment of Diabetic Foot with Ulcer Based on Nano-Silver Antibacterial Dressing. J. Nanosci. Nanotechnol. 2021, 21, 1220–1229. [Google Scholar] [CrossRef]
- Abu-Qdais, H.; Abu-Dalo, M.; Hajeer, Y. Impacts of Nanosilver-Based Textile Products Using a Life Cycle Assessment. Sustainability 2021, 13, 3436. [Google Scholar] [CrossRef]
- Temizel-Sekeryan, S.; Hicks, A.L. Global environmental impacts of silver nanoparticle production methods supported by life cycle assessment. Resour. Conserv. Recycl. 2020, 156, 104676. [Google Scholar] [CrossRef]
- Cui, J.; Shao, Y.; Zhang, H.; Zhang, H.; Zhu, J. Development of a novel silver ions-nanosilver complementary composite as antimicrobial additive for powder coating. Chem. Eng. J. 2021, 420, 127633. [Google Scholar] [CrossRef]
- Kidd, J.; Westerhoff, P.; Maynard, A. Survey of industrial perceptions for the use of nanomaterials for in-home drinking water purification devices. NanoImpact 2021, 22, 100320. [Google Scholar] [CrossRef]
- Gouda, D.; Panda, A.; Nanda, B.K.; Kumar, R.; Sahoo, A.K.; Routara, B.C. Recently evaluated Electrical Discharge Machining (EDM) process performances: A research perspective. Mater. Today Proc. 2021, 44, 2087–2092. [Google Scholar] [CrossRef]
- Joshi, A.Y.; Joshi, A.Y. A systematic review on powder mixed electrical discharge machining. Heliyon 2019, 5, e02963. [Google Scholar] [CrossRef] [Green Version]
- Reece, M.P. The vacuum switch. Part 1: Properties of the vacuum arc. Proc. Inst. Electr. Eng. 1963, 110, 793–802. [Google Scholar] [CrossRef]
- Sheth, M.; Gajjar, K.; Jain, A.; Shah, V.; Patel, H.; Chaudhari, R.; Vora, J. Multi-objective Optimization of Inconel 718 Using Combined Approach of Taguchi—Grey Relational Analysis. In Advances in Mechanical Engineering; Springer: Singapore, 2021; pp. 229–235. [Google Scholar]
- Chaudhari, R.; Vora, J.J.; Pramanik, A.; Parikh, D. Optimization of Parameters of Spark Erosion Based Processes. In Spark Erosion Machining; CRC Press: Boca Raton, FL, USA, 2020; pp. 190–216. [Google Scholar]
- Sarker, B.; Shankar, C. Discriminant Analysis-based Parametric Study of an Electrical Discharge Machining Process. Sci. Iran. 2021. [Google Scholar] [CrossRef]
- Kumar, S.; Singh, R.; Singh, T.P.; Sethi, B. Surface modification by electrical discharge machining: A review. J. Mater. Process. Technol. 2009, 209, 3675–3687. [Google Scholar] [CrossRef]
- Schnick, M.; Füssel, U.; Hertel, M.; Spille-Kohoff, A.; Murphy, A. Metal vapour causes a central minimum in arc temperature in gas–metal arc welding through increased radiative emission. J. Phys. D Appl. Phys. 2009, 43, 022001. [Google Scholar] [CrossRef]
- Zhang, Z.; Ming, W.; Zhang, G.; Huang, Y.; Wen, X.; Huang, H. A new method for on-line monitoring discharge pulse in WEDM-MS process. Int. J. Adv. Manuf. Technol. 2015, 81, 1403–1418. [Google Scholar] [CrossRef]
- Tseng, K.-H.; Yeh, C.-T.; Chung, M.-Y.; Lin, Y.-S.; Qui, N. A study of preparing silver iodide nanocolloid by electrical spark discharge method and its properties. Sci. Rep. 2021, 11, 20457. [Google Scholar] [CrossRef]
- Li, Z.-L.; Xi, X.-C.; Chu, H.-Y.; Xu, L.-Y.; Gao, Q.; Zhao, W.-S. Improving RT-WEDM performance with a radio frequency signal monitoring system. Int. J. Adv. Manuf. Technol. 2022, 118, 391–404. [Google Scholar] [CrossRef]
- Elyass, W.M.; Sharma, V.; Kantak, G.; Alam, M.M. Performance Investigation of Wire EDM Process Parameters. IOP Conf. Ser. Mater. Sci. Eng. 2022, 1224, 012001. [Google Scholar] [CrossRef]
- Yu, S.F.; Lee, B.Y.; Lin, W.S. Waveform Monitoring of Electric Discharge Machining by Wavelet Transform. Int. J. Adv. Manuf. Technol. 2001, 17, 339–343. [Google Scholar] [CrossRef]
- Chen, L. An On-Line Monitoring System for Discharge Condition in LS-WEDM. Machin. Design Manufact. 2017, 2, 128–131. [Google Scholar]
- Liu, K.; Bert, L.; Dominiek, R. Process capabilities of Micro-EDM and its applications. Int. J. Adv. Manufact. Technol. 2010, 47, 11–19. [Google Scholar] [CrossRef] [Green Version]
- Abhilash, P.; Chakradhar, D. Failure detection and control for wire EDM process using multiple sensors. CIRP J. Manuf. Sci. Technol. 2021, 33, 315–326. [Google Scholar] [CrossRef]
- Tseng, K.-H.; Chung, M.-Y.; Chang, C.-Y. Parameters for Fabricating Nano-Au Colloids through the Electric Spark Discharge Method with Micro-Electrical Discharge Machining. Nanomaterials 2017, 7, 133. [Google Scholar] [CrossRef] [PubMed] [Green Version]
- Tien, D.C.; Liao, C.-Y.; Huang, J.-C.; Tseng, K.-H.; Lung, J.-K.; Tsung, T.-T.; Kao, W.-S.; Tsai, T.-H.; Cheng, T.W.; Yu, B.-S.; et al. Novel technique for preparing a nano-silver water suspension by the arc-discharge method. Rev. Adv. Mater. Sci. 2008, 18, 750–756. [Google Scholar]
- Tseng, K.-H.; Ke, H.-K.; Ku, H.-C. Parameters and properties for the preparation of Cu nanocolloids containing polyvinyl alcohol using the electrical spark discharge method. Nanomat. Nanotechnol. 2021, 11, 18479804211035190. [Google Scholar] [CrossRef]
- Liao, C.-Y.; Tseng, K.-H.; Lin, H.-S. Preparation of Metallic Aluminum Compound Particles by Submerged Arc Discharge Method in Aqueous Media. Met. Mater. Trans. A 2013, 44, 91–97. [Google Scholar] [CrossRef]
- Chang, H.; Tsung, T.-T.; Lo, C.-H.; Lin, H.-M.; Lin, C.-K.; Chen, L.-C.; Jwo, C.-S. A study of nanoparticle manufacturing process using vacuum submerged arc machining with aid of enhanced ultrasonic vibration. J. Mater. Sci. 2005, 40, 1005–1010. [Google Scholar] [CrossRef]
- Tien, D.-C.; Tseng, K.-H.; Liao, C.-H.; Tsung, T.-T. Identification and quantification of ionic silver from colloidal silver prepared by electric spark discharge system and its antimicrobial potency study. J. Alloys Comp. 2009, 473, 298–302. [Google Scholar] [CrossRef]
- Tseng, K.-H.; Lee, H.-L.; Tien, D.-C.; Tang, Y.-L.; Kao, Y.-S. A Study of Antibioactivity of Nanosilver Colloid and Silver Ion Solution. Adv. Mater. Sci. Eng. 2014, 2014, 371483. [Google Scholar] [CrossRef] [Green Version]
- Katta, V.K.M.; Dubey, R.S. Green synthesis of silver nanoparticles using Tagetes erecta plant and investigation of their structural, optical, chemical and morphological properties. Mater. Today Proc. 2021, 45, 794–798. [Google Scholar] [CrossRef]
- He, W.-M.; Zhou, Z.; Han, Z.; Li, S.; Zhou, Z.; Ma, L.-F.; Zhang, S.-Q. Ultrafast Size Expansion and Turn-On Luminescence of Atomically Precise Silver Clusters by Hydrogen Sulfide. Angewandte Chem. Int. Ed. 2021, 60, 8505–8509. [Google Scholar] [CrossRef]
- Liaw, J.-W.; Tsai, S.-W.; Lin, H.-H.; Yen, T.-C.; Chen, B.-R. Wavelength-dependent Faraday–Tyndall effect on laser-induced microbubble in gold colloid. J. Quant. Spectrosc. Radiat. Transf. 2012, 113, 2234–2242. [Google Scholar] [CrossRef]
- Tseng, K.-H.; Chen, Y.-C.; Shyue, J.-J. Continuous synthesis of colloidal silver nanoparticles by electrochemical discharge in aqueous solutions. J. Nanopart. Res. 2011, 13, 1865–1872. [Google Scholar] [CrossRef]
- Mann, V.; Hugger, F.; Roth, S.; Schmidt, M. Influence of Temperature and Wavelength on Optical Behavior of Copper Alloys. Appl. Mech. Mater. 2014, 655, 89–94. [Google Scholar] [CrossRef]
- Yang, F.; Liu, Y.; Liu, W.; Yao, K. One-Cycle Control for Pulse Power Generator in Electrical-Discharge-Machining. IEEE Trans. Ind. Electron. 2021, 1. [Google Scholar] [CrossRef]
- Tseng, K.-H.; Chiu, J.-L.; Lee, H.-L.; Liao, C.-Y.; Lin, H.-S.; Kao, Y.-S. Preparation of Ag/Cu/Ti Nanofluids by Spark Discharge System and Its Control Parameters Study. Adv. Mater. Sci. Eng. 2015, 2015, 694672. [Google Scholar] [CrossRef] [Green Version]
- Tseng, K.-H.; Chang, C.-Y.; Cahyadi, Y.; Chung, M.-Y.; Hsieh, C.-L. Development of Proportional–Integrative–Derivative (PID) Optimized for the MicroElectric Discharge Machine Fabrication of Nano-Bismuth Colloid. Micromachines 2020, 11, 1065. [Google Scholar] [CrossRef]
- Tseng, K.-H.; Chen, K.-H.; Chang, C.-Y.; Cahyadi, Y.; Chung, M.-Y. Implementation of a Micro-Electrical Discharge Machine System to Fabricate TiO2 Nanocolloid. Mechatronics 2021, 79, 102649. [Google Scholar] [CrossRef]
- Tseng, K.-H.; Chang, K.-Y.; Chen, M.-J.; Tseng, Y.-K. Novel electrical discharge machining system with real-time control and monitoring for preparing nanoiron colloid. Adv. Mechan. Eng. 2018, 10, 1687814018791705. [Google Scholar] [CrossRef] [Green Version]
- Adedayo, M.R.; Mohammed, M.T.; Ajiboye, A.E.; Abdulmumini, S.A. Pectinolytic activity of Aspergillus niger and Aspergillus flavus grown on grapefruit (citrus Parasidis) peel in solid state fermentation. Glob. J. Pure Appl. Sci. 2021, 27, 93–105. [Google Scholar] [CrossRef]
- Sampson, T. Mycological Survey of Unused Tissue Papers in Public Toilets within a University Campus in Port Harcourt, Rivers State, Nigeria. Saudi J. Pathol. Microbiol. 2021, 6, 447–450. [Google Scholar]
- Mia, R.; Sk, S.; Oli, Z.B.S.; Ahmed, T.; Kabir, S.; Waqar, A. Functionalizing cotton fabrics through herbally synthesized nanosilver. Clean. Eng. Technol. 2021, 4, 100227. [Google Scholar] [CrossRef]
- Tseng, K.-H.; Chang, C.-Y.; Chung, M.-Y.; Tang, Y.-L. Bacteriostatic Substrate by Conductivity Method and Electric Spark Discharge Method Combined with Electrospinning for Silver Dressing. Int. J. Polym. Sci. 2016, 2016, 9425358. [Google Scholar] [CrossRef] [Green Version]
- Xu, L.; Wang, Y.-Y.; Huang, J.; Chen, C.-Y.; Wang, Z.-X.; Xie, H. Silver nanoparticles: Synthesis, medical applications and biosafety. Theranostics 2020, 10, 8996–9031. [Google Scholar] [CrossRef] [PubMed]
- Oladipo, I.C.; Lateef, A.; Azeez, M.A.; Asafa, T.B.; Yekeen, T.A.; Akinboro, A.; Akinwale, A.S.; Gueguim-Kana, E.B.; Beukes, L.S. Green Synthesis and Antimicrobial Activities of Silver Nanoparticles using Cell Free-Extracts of Enterococcus species. Not. Sci. Biol. 2017, 9, 196–203. [Google Scholar] [CrossRef] [Green Version]
- Wasif, A.I.; Laga, S.-K. Use of nano silver as an antimicrobial agent for cotton. AUTEX Res. J. 2009, 9, 5–13. [Google Scholar]
- Fouda, A.; Shaheen, T.I. Silver Nanoparticles: Biosynthesis, Characterization and Application on Cotton Fabrics. Microbiol. Res. J. Int. 2017, 20, 1–14. [Google Scholar] [CrossRef]

| Strain | Culture Medium | |
|---|---|---|
| Name | Code | |
| Bathroom sample | A | MEA |
| Penicillium | P | MEA |
| Aspergillus niger | N | MEA |
| Aspergillus flavus | F | PDA |
| Voltage & Current | V = 100 V, I = 4.2 A | SENS. | Kp = 0.75, Ki = 0.045, Kd = 0.035 |
|---|---|---|---|
| Ton-Toff | 10–10 | Z-Axis | off |
| Capacitor | off | Machining | off |
| Servo | --- | HV | off |
| Diameter of Ag | Anode: 1 mm; Cathode: 2 mm | Beaker | 200 mL |
|---|---|---|---|
| Processing time | 10 min | Filter paper | Advantec |
| Dielectric fluid | DW | ATM | 1 atm |
| Weight | Before W0 (mg) | After W1 (mg) | W0–W1 (mg) | |
|---|---|---|---|---|
| Items | ||||
| E1(anode) | 5081.25 | 5080.96 | 0.29 | |
| E2(cathode) | 3186.96 | 3186.87 | 0.09 | |
| E1 + E2 | 8268.21 | 8267.83 | 0.38 | |
| Temperature(°C) | 25 °C | 28 °C | ----- | |
| Voltage & Current | V = 140 V, I = 11.8 A | SENS | 1/2 |
|---|---|---|---|
| Ton–Toff | 50–50 | Z-Axis | off |
| Capacitor | off | Machining | off |
| Servo | 1/2 | HV | off |
| Diameter of Ag | Anode: 1 mm; Cathode: 2 mm | Beaker | 250 mL |
|---|---|---|---|
| Processing time | 40 min | Filter paper | Advantec |
| Dielectric fluid | DW | ATM | 1 atm |
| Weight | Before W0 (mg) | After W1 (mg) | W0–W1 (mg) | |
|---|---|---|---|---|
| Items | ||||
| E1(anode) | 640.70 | 518.49 | 122.21 | |
| E2(cathode) | 5775.78 | 5773.56 | 2.22 | |
| E1 + E2 | 6416.48 | 6292.05 | 124.43 | |
| Temperature(°C) | 21 °C | 32.6 °C | ----- | |
| Test Liquids | NO.1 | NO.2 | NO.3 | NO.4 | |
|---|---|---|---|---|---|
| Samples | |||||
| Bathroom (A) | 14 | 20 | 14 | 14 | |
| Penicillium (P) | 14 | 16 | 14 | 15 | |
| Aspergillus niger (N) | 14 | 18 | 15 | 15 | |
| Aspergillus flavus (F) | 14 | 15 | 15 | 15 | |
| Test Solution | NO.1 | NO.2 | NO.3 | NO.4 | |
|---|---|---|---|---|---|
| Samples | |||||
| Bathroom (A) | 14 | 20 | 14 | 14 | |
| Penicillium (P) | 17 | 25 | 19 | 25 | |
| Aspergillus Niger (N) | 14 | 25 | 14 | 25 | |
| Aspergillus Flavus (F) | 14 | 17 | 14 | 14 | |
Publisher’s Note: MDPI stays neutral with regard to jurisdictional claims in published maps and institutional affiliations. |
© 2022 by the authors. Licensee MDPI, Basel, Switzerland. This article is an open access article distributed under the terms and conditions of the Creative Commons Attribution (CC BY) license (https://creativecommons.org/licenses/by/4.0/).
Share and Cite
Tseng, K.-H.; Chung, M.-Y.; Chiu, J.-L. Implementation of Micro-EDM Monitoring System to Fabricate Antimicrobial Nanosilver Colloid. Micromachines 2022, 13, 790. https://doi.org/10.3390/mi13050790
Tseng K-H, Chung M-Y, Chiu J-L. Implementation of Micro-EDM Monitoring System to Fabricate Antimicrobial Nanosilver Colloid. Micromachines. 2022; 13(5):790. https://doi.org/10.3390/mi13050790
Chicago/Turabian StyleTseng, Kuo-Hsiung, Meng-Yun Chung, and Juei-Long Chiu. 2022. "Implementation of Micro-EDM Monitoring System to Fabricate Antimicrobial Nanosilver Colloid" Micromachines 13, no. 5: 790. https://doi.org/10.3390/mi13050790
APA StyleTseng, K.-H., Chung, M.-Y., & Chiu, J.-L. (2022). Implementation of Micro-EDM Monitoring System to Fabricate Antimicrobial Nanosilver Colloid. Micromachines, 13(5), 790. https://doi.org/10.3390/mi13050790

